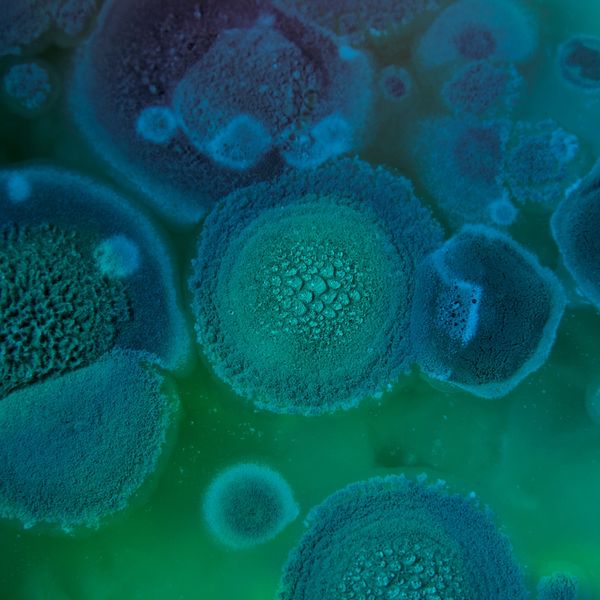

CURRENT LAB PROJECTS

The collaboration of the ARF and p53 tumor suppressors in preventing triple-negative breast cancer
Triple-negative breast cancer (TNBC) has remained a considerable clinical challenge due to the lack of efficacious genetic targets. We need unique effective therapies and accurate biomarkers that can be used to predict patient responses in TNBC. We find that the ARF tumor suppressor is lost alongside p53 mutation in 60% of TNBC. Potentially stemming from the dual loss of ARF and p53, we have observed that type I IFN signaling is elevated in TNBC. We show that this IFN production is being kept in check by the ADAR1 enzyme. Notably, we discovered that ADAR1 is a novel binding partner for ARF. The central premise of this project is that the novel ARF-ADAR1 interaction provides key insights into how these two proteins function in the etiology of TNBC. The research project focuses on the role of this interaction in regulating the type I interferon response and sensitizing TNBC cells to cell death and immune recognition. The overarching hypothesis of the proposed research is that loss of ARF and p53 results in elevated type I IFN signaling and sensitizes cells to ADAR1 depletion.
Collaborators: Dr. Cynthia Ma (WashU), Shunqiang Li (WashU), Jessica Silva-Fisher (WashU), and Alana Welm (Utah)

Identifying drivers of triple-negative breast cancer in African American women
Triple-negative breast cancer is an overly aggressive breast cancer subtype that disproportionately affects African American (AA) women. AA women have an excessive frequency of metastasis to the lung, liver and brain with generally poor survival. These outcome disparities persist even after controlling for socioeconomic factors such as access to care. Notably, genetic sequencing of breast cancers from women of African and European descent did not find significant somatic mutations that would segregate races. We have identified a novel molecular pathway that appears to preferentially drive TNBC in AA. We found that TNBC from AA women appear to activate an innate immune signaling pathway that culminates in the activation of the ADAR1 oncogene and overexpression of the ISG15 oncoprotein. This fundamental finding could point to a novel series of treatment targets for AA TNBC. The lab is now poised to study how ISG15 conjugation to proteins alters disease progression in AA women.
Collaborators: Graham Colditz (WashU), Ying Liu (WashU), Rob West (Stanford), Joy Jiang (WashU)
Role of type I interferon pathway in resistance to CDK4/6 inhibitor in ER+ breast cancer
Cyclin dependent kinase 4/6 inhibitors (CDK4/6i) have revolutionized the treatment landscape for patients with estrogen receptor positive and HER2-negative (ER+/HER2-) breast cancer. Combining CDK4/6i in combination with endocrine therapy has become the front-line treatment of choice in the metastatic setting to improve survival and as adjuvant therapy for those with high-risk early-stage disease to reduce recurrence. However, approximately 15% of ER+/ HER2-breast cancers are intrinsically resistant to CDK4/6i and acquired resistance invariably develops, especially in the metastatic setting. Existing treatments have shown limited efficacy for CDK4/6i resistant ER+/HER2- breast cancer. There is an important unmet need to understand the resistance mechanisms to CDK4/6i for the development of diagnostics and treatments for CDK4/6i resistant disease. In search of pathways that could imbue resistance to CDK4/6i, we observed a significant up-regulation of the type I interferon pathway (IFN) in association with resistance to CDK4/6i in both preclinical and clinical investigations. Interestingly, activation of the IFN pathway has also been consistently reported in association with endocrine resistance. Using CDK4/6i resistant cell lines, we have established that dsRNA sensing increases, ultimately resulting in type I IFNproduction. We will now determine the mechanism for increased IFN production in CDK4/6i resistant cells and uncover key regulatory proteins in the dsRNA sensor pathway.
Collaborators: Cynthia Ma (WashU), Shunqiang Li (WashU), Deb Veis (WashU), Rachel Schiff (Baylor), and Carmine De Angelis (Naples, Italy)

Functional interaction of ADAR1 and MDM2 oncogenes in ferroptosis
As the most well-studied RNA editing enzyme, adenosine deaminase acting on RNA 1 (ADAR1) can drive transcriptomic and proteomic diversity through A(adenosine)-to-I(inosine) RNA editing in human diseases, including cancer. We recently demonstrated an elevated ADAR1-dependent phenotype shared by TNBC, highlighting its potential as a novel therapeutic target. Through RNA sequencing, we identified significant MDM2 upregulation among all cell lines (TNBC and non-TNBC) upon ADAR1 loss. It has recently been shown that MDM2 plays paradoxical roles in cancer, acting as either a therapeutic target with pro-tumorigenic activities, or a tumor-suppressive factor by promoting lipid remodeling and iron-dependent cell death (ferroptosis). We hypothesize that ADAR1 loss in breast can sensitize cancer cells to 1) ferroptosis through induced lipid remodeling, or 2) MDM2 inhibitory treatments through MDM2 upregulation, dictated by their subtypes.
Collaborators: Gary Patti (WashU) and Maxine Ilagen (WashU)

Restoration of ARF tumor suppressor function through peptide mimics
Cancer biologists have long sought to use genetic alterations of tumor cells as novel therapeutic targets. Nearly every anti-cancer drug that has been brought to the clinic using this ideal has targeted oncogenes whose altered activity is thought to drive cancer formation and progression. However, these agents have not appreciably altered the 5-year survival rate of lung cancer. We now seek to switch this thinking. For current and future generations, the prevention or treatment of lung cancer represents a tangible goal in the eradication of this deadly disease. While this goal seems attainable on the surface, the complexity of lung cancer on both a genomic and physiologic level tends to set our sights on the very distant future in reaching this goal. However, recent advances in whole genome sequencing and molecular techniques has provided invaluable tools in the dissection of the lung cancer process. Moreover, the identification of key oncogene and tumor suppressor networks in lung cancer has opened strategic windows to improved patient care. We now propose a highly innovative notion that restoring the ARF tumor suppressor, the second-most mutated tumor suppressor in non-small cell lung cancer (NSCLC), can be clinically impactful. We propose numerous innovative tools and experimental approaches aimed at opening the tumor suppressor field to clinical lung cancer treatment avenues.
Collaborators: Ramaswamy Govindan (WashU) and James Janetka (WashU)

Using high-throughput DNA-barcoded chemical libraries to screen for oncogene inhibitors
The RNA editing enzyme ADAR is a valuable therapeutic target for multiple cancers, including triple-negative breast cancer. ADAR-dependent cancer cell lines share a signature of elevated interferon stimulated gene expression, potentially making it possible to classify ADAR dependent tumors. However, there are currently no selective inhibitors of ADAR. The goal of this project is to identify small molecule inhibitors of ADAR. These ADAR inhibitors will be evaluated for their ability to inhibit ADAR and arrest growth of TNBC cell lines in vitro and tumorigenesis of patient-derived xenograft models of TNBC in vivo. Eventually this work could lead to a clinical trial of ADAR inhibitors for the treatment of TNBC, with patients further stratified by tumoral interferon stimulated gene expression to identify likely responders. Beyond the cell intrinsic effects of ADAR depletion in ADAR-dependent cell lines, it has been shown that depletion of ADAR can overcome resistance to immune checkpoint blockade. This observation supports combining immune checkpoint inhibitors targeting PD-1 or PD-L1 with ADAR inhibitors. Inhibition of ADAR could be the first broadly applicable targeted therapy for the treatment of TNBC. Through this project we will identify and validate a small molecule inhibitor of ADAR, paving the way for clinical trials of ADAR inhibitors for the treatment of TNBC.
Collaborators: Jen Heemstra (WashU), Ron Dolle (WashU), Maxene Ilagen (WashU), James Janetka (WashU), Martin Matzuk (Baylor)
This website uses cookies.
We use cookies to analyze website traffic and optimize your website experience. By accepting our use of cookies, your data will be aggregated with all other user data.